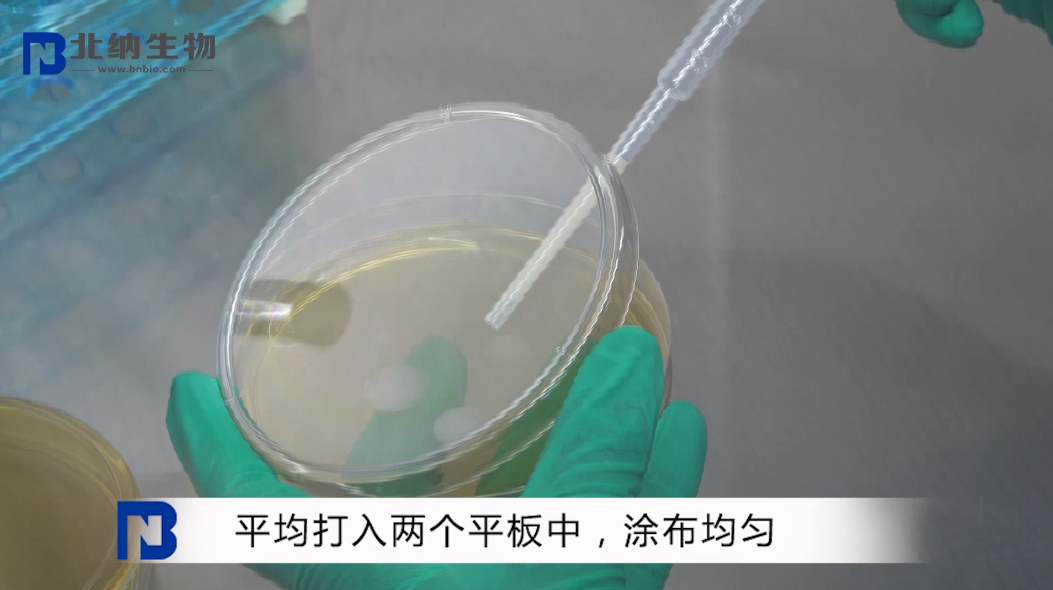
新闻图片11
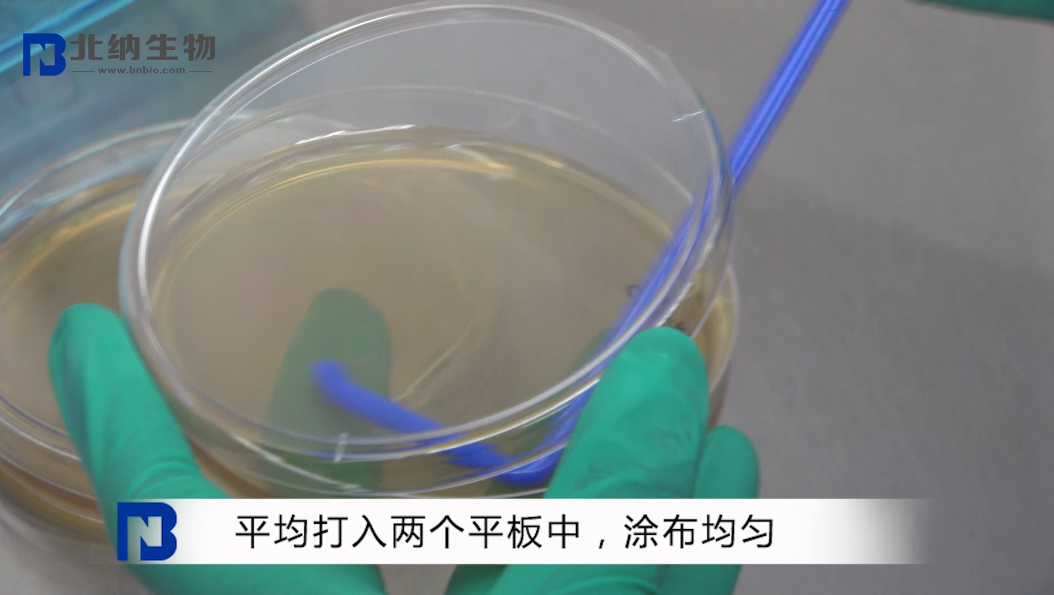
新闻图片12

北京北纳创联生物技术研究院
14 年
手机商铺
商家活跃:
产品热度:
- NaN
- 0.20000000000000018
- 0.20000000000000018
- 2.2
- 2.2
北纳创联痢疾志贺氏菌(冻干粉) Q1030
询价
推荐产品
公司新闻/正文
冻干粉厌氧菌的活化方法
4927 人阅读发布时间:2020-06-02 10:19
没氧还能活?呼吸对我们是一件再自然不过的事情,偏偏它就不喜欢。没错说的就是你,厌氧菌。
厌氧菌是一类在无氧条件下比在有氧环境中生长好的细菌,这么难缠的厌氧「君」来看看北纳技术老师如何收拾它!
1. 打开包装箱,检查安瓿管是否破损,菌株编号与说明书是否一致,若有问题,请拍照留存,并于 24h 内联系客服。


2. 仔细阅读菌种说明书,根据要求准备 5 ml 除氧无菌水,两块新鲜平板,厌氧培养袋和厌氧产气包一套(若无培养条件,可在 4 ℃ 冰箱暂存一周)。



3. 用小砂轮在安瓿管身 1/2 处划两圈,然后用 75% 酒精擦拭管壁消毒后,用手掰断或用镊子敲断安瓿管;


4. 吸取约 0.4 mL 无菌水溶解菌粉,平均打入两块平板中,涂布均匀,同厌氧产气包一起放入厌氧培养袋中,然后按要求置于培养箱中培养;





(菌种常规培养时间:细菌 24-72 h,酵母 72 h,霉菌 5-7 d,大型真菌 7-10 d。)
冻干粉厌氧菌的活化方法,你学会了吗?如果对于实验操作还有疑问或者需要其他的技术指导,欢迎致电 010-58103778,我们一定悉心为您解答。
厌氧菌是一类在无氧条件下比在有氧环境中生长好的细菌,这么难缠的厌氧「君」来看看北纳技术老师如何收拾它!
1. 打开包装箱,检查安瓿管是否破损,菌株编号与说明书是否一致,若有问题,请拍照留存,并于 24h 内联系客服。



2. 仔细阅读菌种说明书,根据要求准备 5 ml 除氧无菌水,两块新鲜平板,厌氧培养袋和厌氧产气包一套(若无培养条件,可在 4 ℃ 冰箱暂存一周)。



3. 用小砂轮在安瓿管身 1/2 处划两圈,然后用 75% 酒精擦拭管壁消毒后,用手掰断或用镊子敲断安瓿管;



4. 吸取约 0.4 mL 无菌水溶解菌粉,平均打入两块平板中,涂布均匀,同厌氧产气包一起放入厌氧培养袋中,然后按要求置于培养箱中培养;

(菌种常规培养时间:细菌 24-72 h,酵母 72 h,霉菌 5-7 d,大型真菌 7-10 d。)
冻干粉厌氧菌的活化方法,你学会了吗?如果对于实验操作还有疑问或者需要其他的技术指导,欢迎致电 010-58103778,我们一定悉心为您解答。




